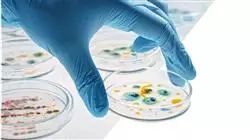
##IMAGE##

Titulación universitaria
La mayor facultad de medicina del mundo”
Presentación del programa
Accede a un programa universitario enfocado en Infectología Clínica y Terapéutica Antibiótica y conviértete en un experto en el manejo de Enfermedades Infecciosas y la optimización del uso de antimicrobianos”
El abordaje de las Enfermedades Infecciosas presenta desafíos cada vez mayores en la práctica clínica actual. Por ello, la emergencia y diseminación de microorganismos resistentes a los antimicrobianos, junto con la aparición de nuevas infecciones y la complejidad del manejo en pacientes inmunocomprometidos, demandan una actualización constante y una especialización profunda por parte de los profesionales de la salud.
Ante este panorama complejo y en constante evolución, TECH Global University presenta el Máster Semipresencial en Infectología Clínica y Terapéutica Antibiótica, un programa universitario diseñado para suministrar a los profesionales de la salud los conocimientos teóricos y las habilidades prácticas necesarias para enfrentar eficazmente los retos de la infectología moderna. Por ende, a través de una metodología flexible y un enfoque multidisciplinario, se profundiza en la Epidemiología, el Diagnóstico Microbiológico, la Patogenia, el tratamiento y la prevención de las principales Enfermedades Infecciosas.
Esta oportunidad académica se distingue por su enfoque en el desarrollo de competencias avanzadas en el diagnóstico clínico y Microbiológico de las Infecciones, la interpretación de pruebas de laboratorio y la selección y administración racional. De esta forma, la modalidad semipresencial incluye un periodo de prácticas clínicas en entornos hospitalarios de referencia, permitiendo a los alumnos aplicar los conocimientos adquiridos en casos reales y bajo la supervisión de infectólogos expertos.
La metodología de este Máster Semipresencial combina la flexibilidad del aprendizaje online con sesiones prácticas y talleres interactivos que facilitan la discusión de casos clínicos complejos, el análisis de guías de práctica clínica y la aplicación de estrategias de optimización del uso de antimicrobianos. Se fomenta el aprendizaje basado en problemas y el análisis crítico de la literatura científica para desarrollar un pensamiento clínico sólido y una toma de decisiones informada. Además, los alumnos tendrán acceso a exclusivas Masterclasses llevadas a cabo por un reconocido Director Invitado Internacional.
Complementa tus estudios online con prácticas presenciales en servicios de Infectología de hospitales de prestigio, donde participarás activamente en el manejo de pacientes con diversas Enfermedades Infecciosas”
Este Máster Semipresencial en Infectología Clínica y Terapéutica Antibiótica contiene el programa universitario más completo y actualizado del mercado. Sus características más destacadas son:
- Desarrollo de más de 100 casos prácticos en infectología clínica y terapéutica antibiótica, presentados por infectólogos expertos y microbiólogos clínicos con amplia experiencia en el manejo de diversas enfermedades infecciosas y la optimización del tratamiento antimicrobiano
- Sus contenidos gráficos, esquemáticos y eminentemente prácticos con los que están concebidos, recogen una información imprescindible sobre aquellas disciplinas indispensables para el ejercicio profesional
- Sistema interactivo de aprendizaje basado en algoritmos para la toma de decisiones sobre situaciones clínicas infecciosas complejas, incluyendo la selección del tratamiento antimicrobiano según el microorganismo, la sensibilidad y las características del paciente
- Guías de práctica clínica actualizadas sobre el abordaje de las diferentes patologías infecciosas, con un enfoque en la optimización del uso de antimicrobianos y la prevención de la resistencia
- Con un especial hincapié en la medicina basada en la evidencia y las metodologías de la investigación en infectología clínica y terapéutica antibiótica
- Todo esto se complementará con lecciones teóricas, preguntas al experto, foros de discusión de temas controvertidos y trabajos de reflexión individual
- Disponibilidad de los contenidos desde cualquier dispositivo fijo o portátil con conexión a internet
- Además, podrás realizar una estancia de prácticas en una de las mejores empresas
Conviértete en un líder en el campo de la Infectología Clínica y la Terapéutica Antibiótica, un área de creciente importancia para la salud pública a nivel global”
En esta propuesta de Máster, de carácter profesionalizante y modalidad semipresencial, el programa universitario está dirigido a la actualización de profesionales de la salud que desarrollan sus funciones en el ámbito de las enfermedades infecciosas y la terapéutica antibiótica, y que requieren un alto nivel de cualificación en este campo. Por lo tanto, los contenidos están basados en la última evidencia científica y orientados de manera didáctica para integrar el saber teórico en la práctica clínica, facilitando la actualización del conocimiento y fortaleciendo la toma de decisiones en el manejo del paciente con infecciones complejas y en la optimización del uso de antimicrobianos. Así las cosas, los elementos teórico-prácticos permitirán al profesional adquirir las competencias necesarias para un abordaje integral y actualizado de la Infectología Clínica.
Gracias a su contenido multimedia elaborado con la última tecnología educativa, permitirán al profesional de la Medicina un aprendizaje situado y contextualizado, es decir, un entorno simulado que proporcionará un aprendizaje inmersivo programado para entrenarse ante situaciones reales. El diseño de este programa está basado en el Aprendizaje Basado en Problemas, mediante el cual deberá tratar de resolver las distintas situaciones de práctica profesional que se le planteen a lo largo del mismo. Para ello, contará con la ayuda de un novedoso sistema de vídeo interactivo realizado por reconocidos expertos.
Esta titulación universitaria te permitirá dominar los tratamientos más actualizados para combatir enfermedades como la Tuberculosis o las Infecciones del Tracto Urinario y Ginecológico de la mujer"

Compagina un excelente aprendizaje teórico con una estancia práctica en un centro hospitalario para situarte a la vanguardia del tratamiento de las Enfermedades Infecciosas”
¿Por qué estudiar en TECH?
TECH es la mayor Universidad digital del mundo. Con un impresionante catálogo de más de 14.000 programas universitarios, disponibles en 11 idiomas, se posiciona como líder en empleabilidad, con una tasa de inserción laboral del 99%. Además, cuenta con un enorme claustro de más de 6.000 profesores de máximo prestigio internacional.

Estudia en la mayor universidad digital del mundo y asegura tu éxito profesional. El futuro empieza en TECH”
La mejor universidad online del mundo según FORBES
La prestigiosa revista Forbes, especializada en negocios y finanzas, ha destacado a TECH como «la mejor universidad online del mundo». Así lo han hecho constar recientemente en un artículo de su edición digital en el que se hacen eco del caso de éxito de esta institución, «gracias a la oferta académica que ofrece, la selección de su personal docente, y un método de aprendizaje innovador orientado a formar a los profesionales del futuro».
Un método de estudio disruptivo, un claustro de vanguardia y su orientación práctica: la clave del éxito de TECH.
Los planes de estudio más completos del panorama universitario
TECH ofrece los planes de estudio más completos del panorama universitario, con temarios que abarcan conceptos fundamentales y, al mismo tiempo, los principales avances científicos en sus áreas científicas específicas. Asimismo, estos programas son actualizados continuamente para garantizar al alumnado la vanguardia académica y las competencias profesionales más demandadas. De esta forma, los títulos de la universidad proporcionan a sus egresados una significativa ventaja para impulsar sus carreras hacia el éxito.
TECH cuenta con los planes de estudio más completos e intensivos del panorama universitario actual.
El mejor claustro docente top internacional
El claustro docente de TECH está integrado por más de 6.000 profesores de máximo prestigio internacional. Catedráticos, investigadores y altos ejecutivos de multinacionales, entre los cuales se destacan Isaiah Covington, entrenador de rendimiento de los Boston Celtics; Magda Romanska, investigadora principal de MetaLAB de Harvard; Ignacio Wistumba, presidente del departamento de patología molecular traslacional del MD Anderson Cancer Center; o D.W Pine, director creativo de la revista TIME, entre otros.
Expertos de talla internacional, especializados en ramas diversas de la Salud, Tecnología, Comunicación y Negocios, forman parte del claustro de TECH.
Un método de aprendizaje único
TECH es la primera universidad que emplea el Relearning en todas sus titulaciones. Se trata de la mejor metodología de aprendizaje online, acreditada con certificaciones internacionales de calidad docente, dispuestas por agencias educativas de prestigio. Además, este disruptivo modelo académico se complementa con el “Método del Caso”, configurando así una estrategia de docencia online única. También en ella se implementan recursos didácticos innovadores entre los que destacan vídeos en detalle, infografías y resúmenes interactivos.
TECH combina el Relearning y el Método del Caso en todos sus programas universitarios para garantizar un aprendizaje teórico-práctico de excelencia estudiando cuando quieras y desde donde quieras.
La mayor universidad digital del mundo
TECH es la mayor universidad digital del mundo. Somos la mayor institución educativa, con el mejor y más amplio catálogo educativo digital, cien por cien online y abarcando la gran mayoría de áreas de conocimiento. Ofrecemos el mayor número de titulaciones propias, titulaciones oficiales de posgrado y de grado universitario del mundo. En total, más de 14.000 títulos universitarios, en once idiomas distintos, que nos convierten en la mayor institución educativa del mundo.
TECH cuenta con el catálogo de programas académicos y oficiales más extenso del mundo y disponible en más de 11 idiomas.
Google Partner Premier
El gigante tecnológico norteamericano ha otorgado TECH la insignia Google Partner Premier. Este galardón, solo al alcance del 3% de las empresas del mundo, pone en valor la experiencia eficaz, flexible y adaptada que esta universidad proporciona al alumno. El reconocimiento no solo acredita el máximo rigor, rendimiento e inversión en las infraestructuras digitales de TECH, sino que también sitúa a esta universidad como una de las compañías tecnológicas más punteras del mundo.
Google ha ubicado a TECH en el top 3% de las empresas tecnológicas más importantes del mundo al concederle su insignia Google Partner Premier.
La universidad online oficial de la NBA
TECH es la universidad online oficial de la NBA. Gracias a un acuerdo con la mayor liga de baloncesto, ofrece a sus alumnos programas universitarios exclusivos, así como una gran variedad de recursos educativos centrados en el negocio de la liga y otras áreas de la industria del deporte. Cada programa tiene un currículo de diseño único y cuenta con oradores invitados de excepción: profesionales con una distinguida trayectoria deportiva que ofrecerán su experiencia en los temas más relevantes.
TECH ha sido reconocida por la NBA, la liga de baloncesto más importante del mundo, como su universidad online oficial.
La universidad mejor valorada por sus alumnos
Los alumnos han posicionado a TECH como la universidad mejor valorada del mundo en los principales portales de opinión, destacando su calificación más alta de 4,9 sobre 5, obtenida a partir de más de 1.000 reseñas. Estos resultados consolidan a TECH como la institución universitaria de referencia a nivel internacional, reflejando la excelencia y el impacto positivo de su modelo educativo.
TECH es la universidad mejor valorada por sus alumnos en el mundo.
Líderes en empleabilidad
TECH ha conseguido convertirse en la universidad líder en empleabilidad. El 99% de sus alumnos obtienen trabajo en el campo académico que ha estudiado, antes de completar un año luego de finalizar cualquiera de los programas de la universidad. Una cifra similar consigue mejorar su carrera profesional de forma inmediata. Todo ello gracias a una metodología de estudio que basa su eficacia en la adquisición de competencias prácticas, totalmente necesarias para el desarrollo profesional.
El 99% de los egresados de TECH consiguen empleo en poco menos de un año tras completar sus estudios.
Máster Semipresencial en Infectología Clínica y Terapéutica Antibiótica
¿Estás listo para convertirte en un experto en infectología clínica y terapéutica antibiótica? TECH Universidad te ofrece la oportunidad de especializarte en este apasionante campo a través de nuestro Máster Semipresencial en Infectología Clínica y Terapéutica Antibiótica. En un mundo donde las enfermedades infecciosas representan un desafío constante para la salud global, la necesidad de profesionales altamente capacitados en el diagnóstico y tratamiento de las infecciones es fundamental. Nuestro programa de Máster se enfoca en brindarte los conocimientos teóricos y prácticos necesarios para convertirte en un experto en infectología clínica y terapéutica antibiótica. Al finalizar el Máster Semipresencial en Infectología Clínica y Terapéutica Antibiótica de TECH Universidad, estarás preparado para enfrentar los desafíos clínicos en el ámbito de la infectología, contribuyendo al bienestar y la salud de los pacientes. No pierdas la oportunidad de avanzar en tu carrera profesional y marcar la diferencia en la lucha contra las enfermedades infecciosas.
Combina lo mejor de ambas modalidades
La modalidad semipresencial de este programa combina la flexibilidad de la educación en línea con la interacción y práctica presencial, permitiéndote obtener una capacitación integral adaptada a tus necesidades. A través de nuestra plataforma en línea, tendrás acceso a los contenidos del Curso Universitario en cualquier momento y desde cualquier lugar, lo que te permitirá estudiar a tu propio ritmo y organizar tu tiempo según tus responsabilidades personales y profesionales. Además, el Máster Semipresencial en Infectología Clínica y Terapéutica Antibiótica incluye encuentros presenciales en nuestras instalaciones, donde podrás interactuar con expertos en infectología, compartir experiencias con otros estudiantes y participar en actividades prácticas que te ayudarán a desarrollar habilidades clínicas fundamentales. Inscríbete ahora en nuestro Máster Semipresencial en Infectología Clínica y Terapéutica Antibiótica y comienza tu camino hacia una especialización de excelencia en el campo de la infectología. ¡Prepárate para convertirte en un líder en la lucha contra las enfermedades infecciosas!







